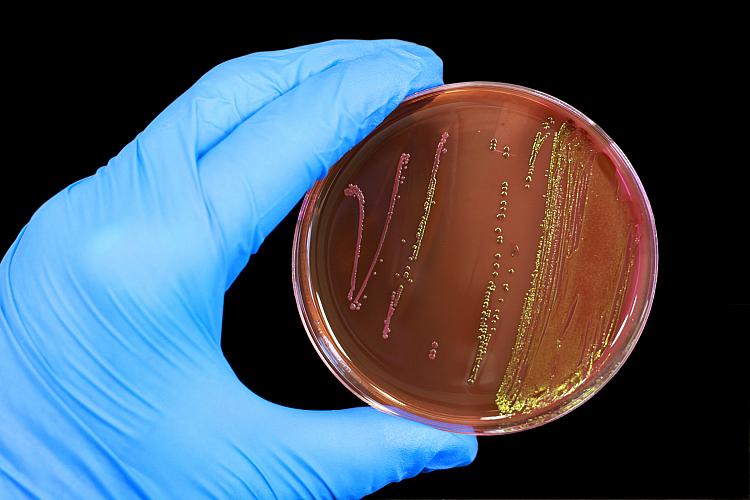

Febre Tifóide
Conheça as causas, sintomas e tratamentos da Febre Tifóide
Por joice
, atualizado em
A falta de higiene e saneamento básico que ainda existem no Brasil, podem ser a grande causadora de algumas doenças, entre elas a febre tifóide, uma doença infecciosa causada por uma bactéria chamada de Salmonella enterica typhi que está presente em água suja, alimentos contaminados. Ela pode se manifestar em qualquer lugar do mundo, mas é mais comum em lugares onde a falta de higiene é constante.
Quando a bacteria entra no organismo, elas passam pelo intestino delgado, e vão diretamente para a corrente sanguínea. Fazendo com que os primentos sintomas comecem a aparecer.
Conheça alguns dos sintomas:
Tudo no corpo é comprometido, mas os principais orgãos a serem afetados são: fígado, baço, vesícula, medula óssea e intestino.
Resumo:
Tratamento
Quando os sintomas aparecem o ideal é procurar um especialista que auxilie na melhor forma de tratamento para a febre tifóide, mas segundo alguns especialistas, o tratamento deve ser a base de antibióticos, hidração (por causa da perda de líquido), agora, se o qaudro do paciente é avançado a indicação será a internação do paciente, e os medicamentos serão administrador via venosa (direto nas veias). Se a pessoa contaminada não receber o tratamento adequado pode correr risco de morte, o que acontece em 15% dos casos, segundo o Ministério da Saúde).
Confira, agora, segundo o site do portal da saúde, algumas dicas de como se prevenir da frebre tifóide:
Como se prevenir?
O saneamento básico, o preparo adequado dos alimentos e a higiene pessoal são as principais medidas de prevenção. Em se tratando de alimentos, observar os seguintes aspectos:
• Consuma água tratada.
• Selecione alimentos frescos com boa aparência, e antes do consumo os mesmos devem ser lavados e desinfetados.
• Para desinfecção, os alimentos crus como frutas, legumes e verduras devem ser mergulhados durante 30 minutos em uma solução preparada com 1 colher de sopa de hipoclorito de sódio a 2,5% para cada litro de água tratada.
• Consuma leite e derivados pasteurizados.
• Não utilize alimentos depois da data de vencimento.
• Lave as mãos regularmente:
– antes, durante e após a preparação dos alimentos;
– ao manusear objetos sujos;
– depois de tocar em animais;
– depois de ir ao banheiro ou após a troca de fraldas;
– antes da amamentação.
• Lave e desinfete todas as superfícies, utensílios e equipamentos usados na preparação de alimentos.
• Proteja os alimentos e as áreas da cozinha contra insetos, animais de estimação e outros animais (guarde os alimentos em recipientes fechados).

Obesidade nos animais de estimação – Como lidar?